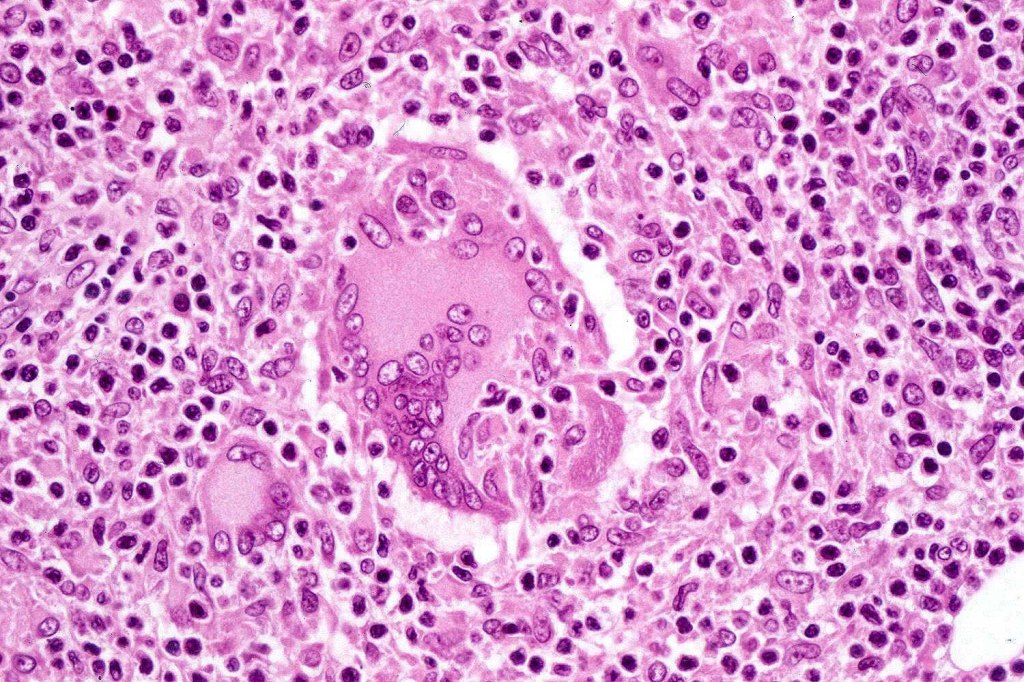
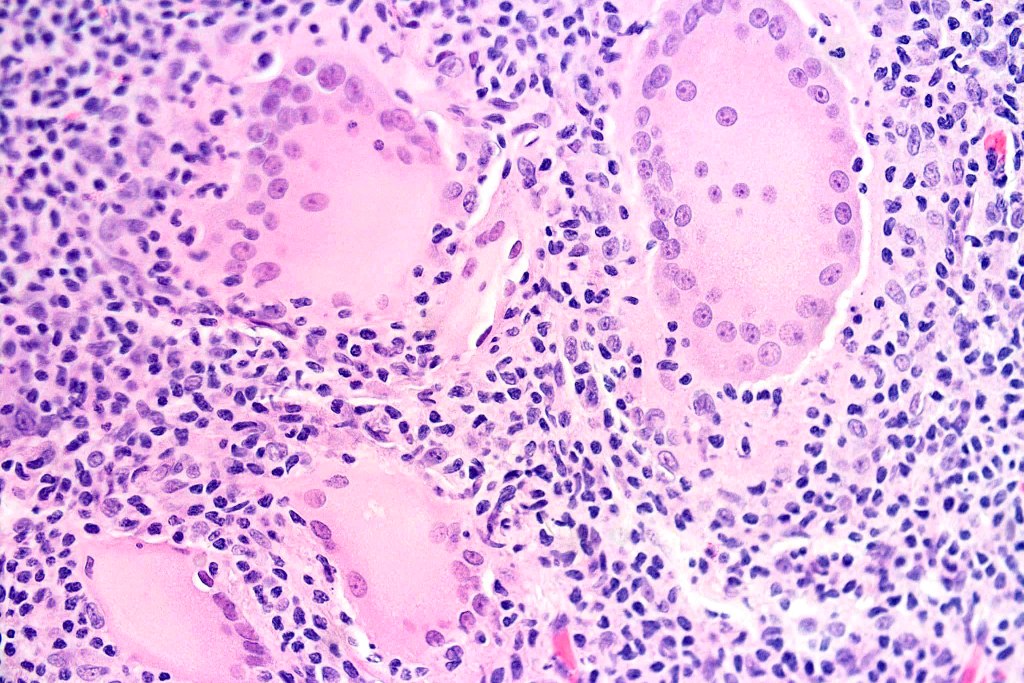
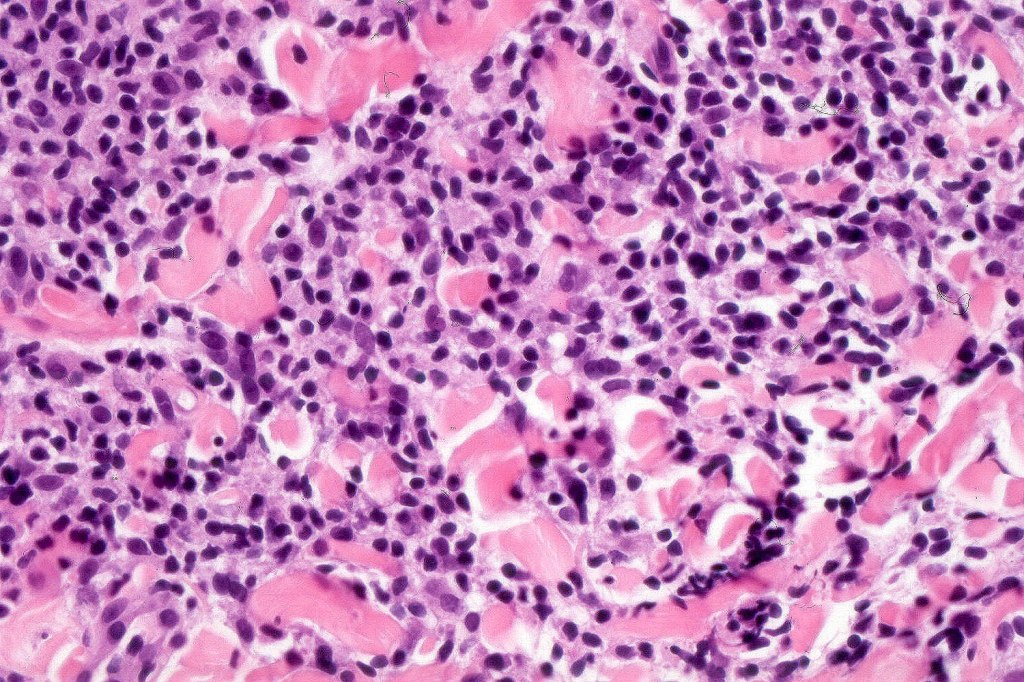

Currently classified as a variant of mycosis fungoides overlapping with granulomatous mycosis fungoides. It has been postulated by some that the entity is a reflection of the site of involvement (axiallae & groins) rather than indicating a separate disease. Due to its rarity, further larger series are needed to substantiate this hypophysis.
Clinical features
•Exceedingly rare variant of mycosis fungoides grouped with granulomatous mycosis fungoides & may reflect anatomical site of involvement
•Predilection for Caucasians
•M>F
•Variable age at presentation
•Axillae & groins predominate but lesions may develop on the trunk, limbs & elsewhere
•Presents with erythematous papules & plaques which slowly progress to distinctive, large, atrophic, pendulous plaques due atrophy and to loss of elastic tissue
•Slowly progressive with 100% 5-year survival
•Variable extracutaneous involvement
•Risk of second lymphoma (including Hodgkin disease) in 50% of patients



Histological features
•Variable MF-like epidermal features
•Established lesions are readily recognizable & characterized by a dense infiltrate throughout the dermis &extending into subcutaneous fat
•Atypical, hyperchromatic lymphocytes, Sezary cells, histiocytes, plasma cells, eosinophils & characteristic multinucleate giant cells (innumerable nuclei resembling a shoal of fish)
•Lymphophagocytosis is generally marked
•Discrete granulomata often evident & in some cases may be the dominant feature obscuring the background lymphomatous infiltrate
•Loss of dermal elastic tissue
•Elastophagocytosis, can be subtle and best demonstrated with an elastic tissue stain (in the 6 cases that I have personally observed, elastophagocytosis has not been present)
•CD4, CD45RO with variable loss of CD3, CD5 & CD7
•CD68 & CD1a +veMonoclonal TCR gene rearrangements

Granulomatous mycosis fungoides by way of a comparison

Differential diagnosis
Dististinction between granulomatous slack skin and granulomatous mycosis fungoides is mostly dependant upon the clinical features of the former condition. With histology, it is a matter of degree more than anything else. Multinucleate giant cells containing innumerable nuclei resembling a shoal of fish is a an important feature of granulomatous slack skin and is not a feature of mycosis fungoides. The presence or absence of elastophagocytosis doesn’t help. Lymphophagocytosis favors granulomatous slack skin. It should be emphasized that the granulomatous component can sometimes be so marked that the underlying lymphoma is missed and a fruitless persuit for an infective pathogenesis can result. Granulomata may be a feature of many other cutaneous lymphomas, mostly T-cell.
Leave a comment